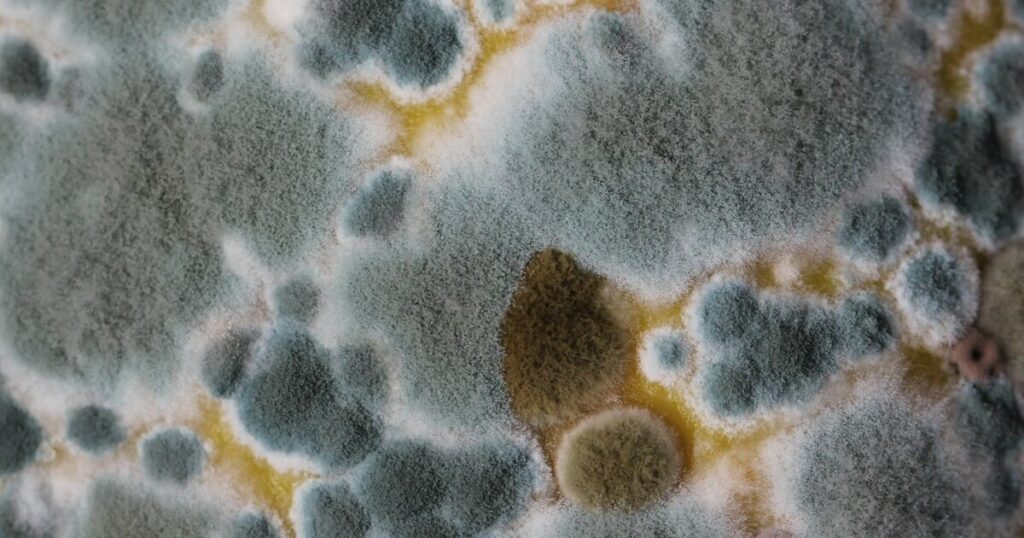

As the chill starts to creep in and frost becomes more frequent, most of us begin tucking our gardens in for winter. But there’s one job that too many gardeners rush—or skip entirely—before shutting the shed door: cleaning gardening tools and equipment. I get it; after months of tending plants, pulling weeds, and harvesting vegetables, the last thing you want to do is scrub down every shovel, rake, and pruner. Still, skipping this step can lead to serious problems come spring, and I’ve seen too many gardeners open their tool sheds in March only to be met with rust, rot, and regret!
Your tools are an extension of your hands in the garden, and keeping them in top shape means they’ll be ready to go when the first warm day arrives. Just like soil health and plant care, tool maintenance plays a big role in long-term gardening success. A clean trowel won’t carry fungal spores to your new seedlings, and a well-oiled pair of pruners won’t snap at the hinge when you need them most. Let’s talk about the reasons cleaning your gardening equipment before winter isn’t just a nice extra—it’s an essential part of good garden stewardship.
Preventing the Spread of Plant Diseases

Dirty tools can carry harmful pathogens from one plant to another, even after the growing season is over. Soil clinging to a spade or plant debris stuck in pruner blades can harbor fungal spores, bacteria, and even viruses that can survive the winter. These pathogens are often the unseen culprits behind mysterious die-offs in spring, especially among tender seedlings and young plants.
By cleaning your tools thoroughly with warm soapy water or a diluted bleach solution, you break the cycle of disease before it has the chance to reemerge. I’ve found this to be particularly important with plants prone to specific diseases—like tomatoes with blight or roses with black spot—where a single contaminated cut can spread infection far and wide.
Reducing Pest Overwintering

It’s easy to forget that your tools can become a hideout for pests over the winter. Small crevices in wooden handles or the undersides of soil-encrusted trowels can harbor insect eggs or larvae. Some species, like earwigs or certain beetles, will happily ride out the cold in these spots, ready to emerge and wreak havoc come spring.
A good scrub followed by drying in the sun removes these pests’ potential winter homes. This also means you’re less likely to introduce unwanted critters into early-season seedlings or freshly turned beds, giving your plants a healthier start without resorting to chemical pest control.
Preventing Rust and Corrosion

Metal tools left with soil and moisture on them are a rust magnet. Once rust sets in, it not only weakens the metal but can also make tools harder to use—shovels won’t cut into soil as cleanly, and pruners may stick when you try to squeeze them. Rust spreads surprisingly fast, even in a cool, dry shed.
Cleaning off dirt and applying a light coat of oil—like linseed or mineral oil—creates a protective barrier against moisture. This is especially important for gardeners in humid climates or areas with wet winters, where condensation can be a real problem inside storage spaces.
Extending the Lifespan of Tools

Every gardener knows that quality tools aren’t cheap, so it makes sense to protect your investment. Soil particles are surprisingly abrasive, and leaving them on tool surfaces can accelerate wear. Wooden handles also benefit from cleaning and occasional oiling, which helps prevent cracking and splintering over time.
Treating your tools with care now means you won’t have to replace them nearly as often. I’ve had the same stainless steel trowel for over a decade, and I’m convinced it’s only survived because I give it a good cleaning before every winter.
Improving Performance in the Spring

Trying to dig or prune with dirty, dull, or gummed-up tools is frustrating. A blade covered in sap from fall pruning will drag and tear rather than slice cleanly, potentially harming your plants. Shovels caked in hardened soil lose their sharp edges and require more effort to use.
Taking time in autumn to clean, sharpen, and lubricate your equipment ensures that when you grab a tool in spring, it’s ready to perform. There’s nothing better than starting the growing season with everything in perfect working order!
Avoiding Mold and Mildew in Storage
Moisture trapped in soil or plant debris left on tools can encourage mold growth in your storage area. Mold not only damages tools but can spread to other items in your shed, including wooden shelving, seed packets, and even stored bulbs. Some molds release spores that can cause allergies or respiratory irritation.
By thoroughly cleaning and drying tools before putting them away, you remove the organic matter that mold feeds on. Storing them in a well-ventilated space further reduces the risk of mold problems over the winter.
Supporting Soil Health

While it might sound odd, cleaning your tools also supports the health of your garden soil. Soil from different parts of your yard—or from other gardens entirely—can contain different microbe communities. Transferring soil unintentionally with your tools can disrupt the balance in your beds or introduce unwanted pests.
This is particularly important if you use your tools at community gardens or share them with friends. A quick cleaning before winter ensures you’re not accidentally altering your soil’s ecosystem when planting season returns.
Maintaining Safety

Dirty or poorly maintained tools can be dangerous. A rusty pruner can cause deep, jagged cuts that are more prone to infection. Splintered handles from neglected maintenance can injure your hands, and slippery sap-covered grips can cause accidents.
Cleaning your tools not only makes them easier to handle but also gives you a chance to inspect for damage. Spotting a crack in a rake handle now means you can fix it before it snaps in the middle of a spring cleanup.
Saving Time Next Season

There’s something satisfying about opening your shed in spring and finding all your tools clean, organized, and ready to go. It saves time and frustration when you can simply grab what you need without having to scrub off months-old dirt or fight with stuck blades.
This preparedness lets you take full advantage of those early warm days when planting and pruning are most productive. It’s one less barrier between you and getting your hands in the soil right away.
Protecting Pollinator Habitats

While it might not be the first thing that comes to mind, dirty tools can affect pollinators indirectly. If contaminated tools spread plant diseases to early-season blooms, it can reduce the food sources available to bees and butterflies emerging from winter dormancy.
Keeping tools clean helps protect these essential garden visitors by maintaining healthy, disease-free plants in your yard. In a time when pollinator populations are under pressure, every bit of support counts.
Encouraging Sustainable Gardening Practices

A garden is more than just plants—it’s part of a larger ecosystem. Taking care of your tools extends their life, reduces waste, and minimizes the need for frequent replacements, which in turn reduces the environmental impact of manufacturing and shipping new ones.
By making tool cleaning a regular part of your seasonal routine, you’re modeling sustainable habits that benefit your garden, your wallet, and the planet. It’s a small act with a big ripple effect in the gardening world.

